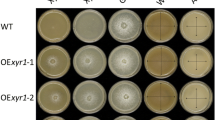

Abstract
Xylitol, a naturally occurring five-carbon sugar alcohol derived from d-xylose, is currently in high demand by industries. Trichoderma reesei, a prolific industrial cellulase and hemicellulase producing fungus, is able to selectively use d-xylose from hemicelluloses for xylitol production. The xylitol production by T. reesei can be enhanced by genetic engineering of blocking further xylitol metabolism in the d-xylose pathway. We have used two different T. reesei strains which are impaired in the further metabolism of xylitol including a single mutant in which the xylitol dehydrogenase gene was deleted (∆xdh1) and a double mutant where additionally l-arabinitol-4-dehydrogenase, an enzyme which can partially compensate for xylitol dehydrogenase function, was deleted (∆lad1∆xdh1). Barely straw was first pretreated using NaOH and Organosolv pretreatment methods. The highest xylitol production of 6.1 and 13.22 g/L was obtained using medium supplemented with 2 % Organosolv-pretreated barley straw and 2 % d-xylose by the ∆xdh1 and ∆lad1∆xdh1 strains, respectively.
Similar content being viewed by others
Avoid common mistakes on your manuscript.
Introduction
Large amount of lignocellulosic wastes are produced by different industries such as forestry, agriculture, and food during pre-harvest, post-harvest, and the processing steps [1]. These lignocellulosic wastes are mainly composed of cellulose, hemicellulose, and lignin. Recently, there is high interest in using hemicellulose-rich wastes generated as by-products from agricultural and food industries to produce high value bio-product such as xylitol, d-mannitol, and d-xylonic acid [2, 3]. Additionally, these wastes can be further processed to extract their monomeric sugars, such as d-xylose and l-arabinose which can be fermented to ethanol by microorganisms able to utilize pentose sugars [1, 4]. Pretreatment of lignocellulosic waste, however, is a prerequisite step since lignin is the main barrier for accessing cellulose and hemicellulose by the catalyzing enzymes [5, 6].
d-Xylose as the monomeric five-carbon sugar creates the backbone of the β-1,4-xylan which is the major constituent of plant hemicelluloses [1]. Different microorganisms including bacteria and fungi can use xylan as a carbon source for their growth. These microorganisms hydrolyze β-1,4 linkages in xylan to produce oligomers using xylanases. Ultimately, the oligomers can be further hydrolyzed into d-xylose monomers by β-xylosidase [1]. In fungi such as Trichoderma reesei, d-xylose enters into a three-step pathway before entering into the pentose phosphate pathway (PPP) (Fig. 1) [7]. In the first step, d-xylose will be converted by d-xylose-reductase (XYL1; EC 1.1.1.21) into the five-carbon sugar alcohol xylitol [8]. Xylitol will be then used to produce d-xylulose by xylitol dehydrogenase (EC 1.1.1.9). Finally, d-xylulose will be converted into d-xylulose-5-phosphate by d-xylose kinase (EC 2.7.1.17) and enters into the PPP [7]. Deletion of the xylitol dehydrogenase gene xdh1 in T. reesei (∆xdh1) only partially impairs the growth of the ∆xdh1 strain on d-xylose and reduces the growth rates to about 50 % [7]. Thus, it was suggested that a second enzyme with xylitol dehydrogenase activity in T. reesei would exist. The responsible enzyme was identified as the l-arabinitol-4-dehydrogenase (LAD1) which could partially compensate for the loss of XDH1 function in ∆xdh1 strains and consequently a strain with deletions in both dehydrogenases (∆lad1∆xdh1) failed to grow on d-xylose and xylitol [7]. Xylitol is also the first common intermediate of the interconnected d-xylose and l-arabinose pathways [4, 8].
T. reesei d-xylose and l-arabinose catabolism pathway and created T. reesei single (∆xdh1) and double mutant (∆lad1∆xdh1) strains (modified from Seiboth et al. [8])
Xylitol as a naturally occurring polyalcohol has been used as a natural sweetener due to its high sweetening power for years. Besides this, it has been used as an anticariogenic for oral health and caries prevention by preventing the growth of microorganisms involved in tooth decay [2]. Additionally, oral administration of xylitol in animal models showed to be important for bone tissue and affect bone metabolism and ultimately increase bone density [9]. According to Prakasham et al. [10], the annual global market for xylitol is $340 million and is estimated to grow. Xylitol can be produced either chemically using pure d-xylose or by applying biotechnological processes including fermentation by microorganisms and/or enzymatic approaches. Although chemical production of xylitol has some disadvantages such as high cost and energy investment, there is still a case for its industrial production. Biotechnological methods for large-scale xylitol production which can replace the chemical method, however, are not yet available [11]. Significant efforts, many of which have been successful, have been made to improve xylitol production by different microorganisms. These include genetic engineered bacteria, yeast, and fungi [7, 12–14]. Besides, many recent studies focused on using pretreated agricultural residues as the feedstock for xylitol production by xylitol hyper-producing microorganisms. To this end, different lignocellulosic biomass such as corn cobs [15], sugarcane bagasse [11], and corn stover [16] were pretreated applying different pretreatment methods, and ultimately, the hydrolyzates were used for the xylitol production.
In our study, we investigated the effects of two different pretreatment methods including Organosolv and NaOH pretreatment of barley straw. The hydrolyzates were used as the feedstock for xylitol production by two metabolically engineered T. reesei strains including single (∆xdh1) and double (∆lad1∆xdh1) deletion strains. To maximize xylitol production by these strains, different media compositions were also tested. Additionally, hydrolysis efficiency of the enzymes produced by the mutant strains was investigated using untreated and pretreated barley straw.
Materials and Methods
Chemicals
Chemicals and reagents used in the study were of analytical grade. Barley straw (obtained from Gammondale Farm, Thunder Bay, ON, Canada) was first ground in a Wiley mill, then sieved to less than 20 mesh, and dried in an oven to a constant weight at 70 °C before use.
Pretreatment of Barley Straw
Barley straw (50 g of previously ground) was subjected to Organosolv pretreatment (in Dr. Charles Xu’s lab, Lakehead University, Thunder Bay, ON, Canada) using a 1-L autoclave reactor (Autoclave Engineers, USA) and according to the method described by Cheng et al. [17]. Alkali treatment of ground barley straw (2 % w/v) was done according to the method described by Deshpande et al. [18].
Particle Size and Particle Size Distribution of Untreated and Pretreated Barley Straw
Particle size measurement was done in the instrumentation lab at Lakehead University (Thunder Bay, ON, Canada) using a Malvern Mastersizer 2000 particle size analyzer with Hydro 2000MU (Malvern Instruments Ltd, UK). An ultrasonic probe disperser was applied to all the sample measurements due to the high electrostatic charge of the samples. The experiment was done using approximately 5 g of barley straw (untreated, Organosolv- or NaOH-pretreated) according to the manufacture’s instruction. The size of the particles were recorded and analyzed three times by the provided manufacture’s software using the same SOP.
FTIR Analyses of Untreated and Pretreated Barley Straw
To investigate the modification of lignin functional groups of pretreated barley straw, Fourier transform infrared spectroscopic (FTIR) spectra (4,000 to 800 cm−1) were obtained and compared to untreated barley straw (Instrumentation Lab, Lakehead University, Thunder Bay, ON, Canada) using a Tensor 37 FTIR (Bruker Optics, Germany) with a resolution of 4 cm−1 and 32 scans per sample. The experiment was done using approximately 2 mg of each sample and applying a MIRacle ATR accessory with high-pressure clamp (PIKE Technologies, Madison, WI, USA).
Strains and Culture Conditions
T. reesei knockout mutant xdh1 (∆xdh1) strain and double knockout mutant lad1 xdh1 (∆lad1∆xdh1) strain were used in xylitol production experiments [7]. The strains were grown and maintained on potato dextrose agar (PDA). Strains were grown in 50 mL of medium described by Mandels and Andreotti [19] (MA-medium) in 250 mL flasks using a rotary shaker (200 rpm) at 30 °C supplemented with different carbon sources at a final concentration of 2 % (w/v). The media was autoclaved at 121 °C (15 lb psi) for 15 min.
Inoculum Preparation and Xylitol Production by Two Mutant T. reesei Strains
The greenish conidia from the mutant T. reesei strains incubated for 14 days at 30 °C on PDA plates was suspended in 5 mL of sterile saline solution (0.9 % w/v, NaCl). Ultimately, gentle filtration was applied in order to separate the spores from the mycelia using 12 layers of lens paper (Fisher Scientific, Canada), followed by spore counting using a Petroff-Hausser cell counter (American Optical, USA). The isolated spores were used to inoculate (1.0 × 107, final concentration) 250 mL flasks containing 50 mL medium (MA-medium) with 2 % glycerol (w/v) as the carbon source and incubated at 30 °C for a total of 48 h. These pre-grown mycelia were then washed three times by MA-medium without any carbon source to remove any residual glycerol. Equal amounts of mycelia (1 g) were then transferred into 250 mL flasks containing 50 mL xylitol production media (MA-medium) in which 2 % glycerol (w/v) was substituted with 2 % (w/v) barley straw (untreated, Organosolv- or NaOH-pretreated) with or without 2 % (w/v) monomeric carbon sources (either d-glucose or d-xylose). Two biological replicates were done for each experiment. To examine xylitol production, a time course trial of 168 h was conducted at 30 °C. Samples of 500 μL each were taken from each of the flasks every 24 h and were centrifuged at 16,060 rcf for 5 min. The supernatant was used as the source for the xylitol measurement as well as xylanases enzyme assays [20].
Analytical Analyses
During the 168-h incubation period, samples of 500 μL were extracted at 24 h intervals and centrifuged (16,060 rcf for 5 min). The resultant supernatants were kept at 4 °C for further substrate and product analyses. These supernatants were used to determine extracellular concentration of xylitol produced by the two mutant T. reesei strains. The supernatant was appropriately diluted, followed by filtration using 0.2 μm syringe filters (Ultident, Canada). Ultimately, they were analyzed by high-performance anion exchange chromatography with pulsed amperometric detection (HPAE-PAD) using a Dionex ICS3000 system (Dionex, Sunnyvale, CA, USA) equipped with a 3 × 150-mm CarboPac PA20 Carbohydrate Column and Guard (Dionex, Sunnyvale, CA, USA); 0.52 M NaOH (isocratic) eluent was used at a flow rate of 0.5 mL min−1 and a full loop injection volume of 25 μL. The column was maintained at 30 °C, and a gold (Au) electrode with quadruple potential was used for separation. Applying the same method, either d-Xylose or d-glucose concentrations in the supernatant were measured only whenever either of them presented in the supernatant (xylitol production experiment, “Xylitol Production by the Mutant T. reesei Strains and the Effect of Different Pretreatment Methods on the Production” section). The method was modified in order to determine d-glucose, d-xylose, and l-arabinose concentrations in the supernatant in the case of enzymatic hydrolysis of barley straw (“Xylanases Activity of the Mutant T. reesei Strains and the Effect of Different Pretreatments on the Activity” section), where these sugars were released and mixed together. To this end, 0.36 M NaOH was used as eluent.
Enzyme Assays
Xylanases (EC 3.2.1.8) activity of the two T. reesei mutant strains was determined by measuring the release of reducing sugars (RS) using a dinitrosalicylic acid method (DNS) [21]. Twenty-five microliters of 1 % (w/v) birch wood xylan dissolved in 50 mM sodium citrate buffer (pH 4.8) was used as the substrate. Ultimately, 25 μL of suitably diluted enzyme solution (culture supernatant) was added to the reaction and incubated at 50 °C for 10 min. One hundred fifty microliters of DNS solution was used to stop the reaction. The reaction was kept in a boiling water bath for 5 min, and the absorbance was read at 570 nm [20]. The xylanase activity was defined as international units per milliliter, and 1 IU was the amount of enzyme that released 1 μmol of reducing sugar (xylose) equivalents per min calculated using a xylose standard curve. The background reducing sugars found in the enzyme supernatant were excluded from the results by adding negative controls (enzyme control) in the assay. The absorbance of the enzyme control sets and substrate control was subtracted from the absorbance of the activity assay [20].
Total cellulase activity was also measured using the DNS method and applying a microplate-based filter paper assays according to a method described previously [22]. Total reducing sugars released during the assay were estimated as glucose equivalents and represented as filter paper units (FPU) per milliliter where 1 FPU is defined as the amount enzyme that released 1 μmol of glucose equivalents per min in the assay reaction [23]. The protein concentration in the supernatant was measured using the Fermentas Bradford Reagent according to the manufacturer’s protocol and also a Fermentas bovine serum albumin standard set as the standard (Fermentas, Canada).
Enzymatic Hydrolysis of Barley Straw by Two T. reesei Mutant Strains
Hydrolysis activity of the mutant T. reesei strains was investigated using 3 % (w/v) of barley straw (untreated, Organosolv- or NaOH-pretreated) according to the method described before [24]. Substrate hydrolysis was catalyzed using the culture supernatants of the mutant strains grown on MA-medium supplemented with 1 % microcrystalline cellulose (MCC) for 168 h. Enzymatic hydrolysis of barley straw was started with 3 % substrate concentration in 50 mM sodium citrate buffer at pH 5.0 (supplemented with 1 mM sodium azide to prevent microbial contamination) and equal amount of crude enzyme dosage for both strains at 50 °C for 120 h. A negative control was added in which the crude enzyme was replaced with the buffer. Samples were taken every 24 h and subjected to determination of released RS as well as the d-glucose, d-xylose, and l-arabinose levels in the supernatant. The released reducing sugars were detected by the DNS method while the d-glucose, d-xylose, and l-arabinose concentrations were measured using HPAE-PAD.
Data Processing and Statistical Analysis
All experimental points presented in the study are the average values of two independent repeats. Microsoft Excel spreadsheet was used to collect the data and for determination of average and standard error of the mean. The graphs were created using the software PRISM 5.0.
Results and Discussion
Effect of Pretreatment on Particle Size and Particle Size Distribution of Barley Straw
The effect of two different pretreatment methods on barley straw particle size distribution is shown in Fig. 2a. The particle size profile of untreated barley straw presented a main peak with the volume percentage about 8.5 % at 700 μm. Additionally, smaller particle size with very low percentage of particles was observed for untreated barley straw in the region ranging from 2 to 110 μm. However, different profiles were obtained for NaOH- and Organosolv-pretreated barley straw compared to untreated barely straw, and the main peak was shifted to 150 and 70 μm for the treatments, respectively (Fig. 2a). In the bioconversion process, pretreatment of lignocellulosic biomass becomes an essential step before hydrolysis takes place. This is due to the fact that the hydrolysis of untreated lignocellulosic biomass is very slow which leads to lower product yield [1]. It has been shown that particle size affects bioconversion of lignocellulosic biomass in which smaller particle size positively correlated with higher conversion rates [25]. For example, a study by Pedersen and Meyer [26] showed that reduced particle size in pretreated wheat straw with about 53–149 μm particle sizes (oxidized) released more d-glucose and d-xylose compared to the untreated sample. Our results (“Enzymatic Hydrolysis of Biomass by the Mutant T. reesei Strains” section) also showed higher amounts of reducing sugars released from both pretreated barley straw compared to the untreated sample. However, it has been suggested that other important factors such as cellulose crystallinity also plays a major role in the hydrolysis process beside the particle size in pretreated biomass [1, 27].
Study the effect of two pretreatment methods on barley straw. a Particle size distribution of untreated barley straw as well as NaOH- and Organosolv-pretreated. b and c FTIR spectra for untreated and NaOH- and Organosolv-pretreated barley straw. b General trends of chemical changes in barley straw after the treatments and c selected FTIR spectra (1,800 to 800 cm−1) region for functional changes after the treatments
FTIR Analyses of Untreated and Pretreated Barley Straw
The FTIR was used to qualitatively determine the chemical changes in pretreated barley straw. The FTIR spectra for NaOH- and Organosolv-pretreated barley straw samples were compared to untreated barley straw and shown in Fig. 2b, c while the main assignments of functional groups in FTIR bands are listed in Table 1. The general trends of chemical changes in barley straw after the pretreatments (4,000 to 800 cm−1) are compared to untreated barley straw (Fig. 2b). The peaks around 3,350 cm−1 are associated with O–H stretching of hydrogen bonds in cellulose [28, 29]. Untreated and NaOH-pretreated barley straw showed similar absorption peaks, however, at decreased levels in the Organosolv-pretreated barley straw. This indicated that similar to untreated barley straw, most of the crystalline cellulose in NaOH-pretreated barley was not disrupted by the treatment. Organosolv pretreatment, however, showed to be a more effective method and decreased the crystallinity of barley straw. The band at 2,900 cm−1 is attributed to C–H stretching of methylene cellulose which was less intense in both pretreatment methods used in this study [28, 30]. The bands at 1,200–1,000 cm−1 representing structural features of carbohydrates and polysaccharides were also less intense in the pretreated barley straw compared to the untreated sample [28, 31] (Fig. 2c). The peaks at 1,610 and 1,516 cm−1 are attributed to aromatic skeletal stretching in lignin, and the bands at 2,860, 1,460, and 1,425 cm−1 are attributed to C–H deformation within the methyl groups of lignin [28, 32]. Both pretreated barley straw samples showed decreased adsorption in bands compared to the untreated sample suggesting that lignin was removed in the pretreated samples. The band at 1,720 cm−1 is attributed to ester linkage C=O which is categorized as hemicellulose-lignin linkage and/or the acetyl group existing in hemicellulose structure [28, 29]. Our results showed that the band adsorption in the Organosolv-pretreated barley straw decreased suggesting that the linkage between lignin and hemicellulose was removed. However, NaOH-pretreated barley straw showed almost the same band adsorption as untreated barley straw. The decrease in the 1,720-cm−1 band is suggested to be related to delignification of hemicellulose in the pretreated sample [29]. The band at 1,640 cm−1 attributed to the aldehyde group in hemicellulose and the decrease in the band represents hemicellulose hydrolysis which was the case for the both pretreatment methods used in the study [29] (Fig. 2c).
Xylitol Production by the Mutant T. reesei Strains and the Effect of Different Pretreatment Methods on the Production
Two T. reesei strains which are blocked in the step from xylitol to d-xylulose were used for the xylitol production. Strain ∆xdh1 is partially impaired in xylitol oxidation while strain ∆xdh1∆lad1 is completely blocked in the further conversion of xylitol. Barley straw was used as the complex medium and also as an example for the application of agricultural waste. This would be essential to investigate since usually complex lignocellulosic wastes (agriculture or forestry-based) are targeted for bio-product productions by different microorganisms. In this study, MA-medium was supplemented with barley straw containing relatively high hemicellulose content (26.46 ± 3.67 %). Barley straw was either pretreated with Organosolv or 2 % NaOH. Alkali or Organosolv pretreatment methods have been shown to be able to remove lignin and possibly also part of the hemicellulose fraction and enhance saccharification rate by increasing cellulose accessibility to cellulases [5]. The xylitol production by the two T. reesei strains using untreated, Organosolv- and NaOH-pretreated barley straw is shown in Fig. 3a–f. The media was also supplemented by either 2 % d-glucose or d-xylose in order to enhance the production and increase the cell growth on the complex media. As shown in Fig. 3a, b, very low xylitol production was observed using untreated, Organosolv- and NaOH-pretreated barley straw in the absence of the supplementary sugars (d-glucose or d-xylose). The maximum production of 1.25 and 1.13 g/L was obtained for single and double deletion strains using untreated and NaOH-pretreated barley straw after 96 and 168 h of incubation, respectively (Fig. 3a, b). Our results showed that adding d-glucose to the complex media did not improve xylitol production by either strain (Fig. 3c, d). This confirmed that xylitol production is through a separate pathway and does not directly correlate with the cell growth on d-glucose. A study by Prathumpai et al. [33] also showed that wild-type or mutant Aspergillus nidulans strains produced very low amount of xylitol (58.7 and 12.7 mg/L, respectively) either in the presence or absence of d-glucose in the fermentation medium. The highest xylitol production, however, was obtained when the media were additionally supplemented with d-xylose (Fig. 3e, f). For the ∆xdh1 strain, the maximum xylitol production of 6.1 g/L was obtained after 96 h of incubation using MA-medium supplemented with 2 % Organosolv-pretreated barley straw and 2 % d-xylose (Fig. 3e). The ∆xdh1∆lad1 strain, however, produced 2.17-fold more xylitol (13.22 g/L) compared to the single mutant strain after 168 h of incubation using the same medium condition (Fig. 3f). This is in a good accordance with the previous studies where a partial compensation for the loss of xdh1 function in the ∆xdh1 strain was observed [7]. Lower xylitol was produced using other media compositions including untreated and NaOH-pretreated barley straw supplemented with d-xylose. This suggests that the Organosolv pretreatment method favors xylitol production by both strains from barley straw. A study by Prakash et al. [34] also showed that higher xylitol production by Debaryomyces hansenii was observed when the hemicellulose fraction from sugarcane bagasse was supplemented with 2 % d-xylose.
Xylitol production by two mutant T. reesei strains using barley straw. a, b Xylitol production by single or double mutant strains on MA-medium supplemented with 2 % barley straw, respectively. c, d Xylitol production by single or double mutant strains on MA-medium supplemented with 2 % barley straw in addition to 2 % d-glucose, respectively. e, f Xylitol production by single or double mutant strains on MA-medium supplemented with 2 % barley straw in addition to 2 % d-xylose, respectively. As the controls, xylitol production by both strains was measured using MA-medium without any carbon source (MA, in a and b), or MA-medium supplemented either with 2 % d-glucose (MA + Glu, in c and d) or d-xylose (MA + Xyl, e and f). d-Glucose (c, d) or d-xylose consumption by both strains (e, f) are also measured over the time point study. Data are represented as the mean of two independent experiments, and error bars denote standard error of the mean
d-Glucose and d-xylose consumption by the two strains were monitored over the time course study (Fig. 3c–f). As expected, both strains showed high d-glucose consumption within a short time and d-glucose concentration in the medium decreased from 20 g/L to about 5 g/L after the first 24 h of incubation (Fig. 3c, d). Our results showed that d-glucose concentration in the medium remained at almost the same level over the rest of the incubation times. However, the two strains showed different trends for d-xylose consumption (Fig. 3e, f). d-Xylose was slowly used by the ∆xdh1 strain over the time point study, and the concentration gradually decreased from 20 to about 0.32 g/L after 168 h of incubation (Fig. 3e). However, for the ∆xdh1∆lad1 strain, no major changes in d-xylose concentrations were observed over the whole period, and about the same amount of d-xylose was found at the end of the cultivation (Fig. 3f).
Xylanase Activity of the Mutant T. reesei Strains and the Effect of Different Pretreatments on the Activity
Xylanase activity of the two T. reesei strains grown on MA-media supplemented with barley straw (untreated or pretreated) and monomeric sugars (“Xylitol Production by the Mutant T. reesei Strains and the Effect of Different Pretreatment Methods on the Production” section) was also investigated here (Fig. 4a–f). The single ∆xdh1 strain showed high xylanase activity using MA-media supplemented with only 2 % barley straw (Organosolv- or NaOH-pretreated) with the highest activity at about 336 IU/mL after 168 h of incubation using MA-medium supplemented with NaOH-pretreated barley straw (Fig. 4a). The ∆xdh1∆lad1 strain, however, showed high xylanase activity only when the MA-medium was supplemented with Organosolv-pretreated barley straw at about 292 IU/mL after 120 h of incubation (Fig. 4b). Both strains showed the same trend for xylanase activity when the medium was additionally supplemented with 2 % d-glucose (Fig. 4c, d). Our results indicated that addition of d-glucose lowers the xylanase activity in most cases except when NaOH-pretreated barley straw was used. In this case, xylanase activities of 253 and 267 IU/mL were obtained for ∆xdh1 and ∆xdh1∆lad1 strains grown on MA-medium supplemented with 2 % NaOH-pretreated barley straw and 2 % d-glucose after 144 and 168 h of incubation, respectively (Fig. 4c, d). Lower xylanase activity was also obtained when the medium was supplemented by d-xylose (Fig. 4e, f). However, the ∆xdh1∆lad1 strain showed higher activity compared to the single ∆xdh1 strain. Specifically, the ∆xdh1∆lad1 strain grown on MA-medium supplemented with 2 % Organosolv-pretreated barely straw and 2 % d-xylose showed high xylanase activity at about 338 IU/mL after 144 h of incubation (Fig. 4f). This is in accordance with the xylitol production results (Fig. 3f, “Xylitol Production by the Mutant T. reesei Strains and the Effect of Different Pretreatment Methods on the Production” section) where the highest xylitol production by the ∆xdh1∆lad1 strain was obtained.
Xylanase activity of two mutant T. reesei strains grown on MA-media used in xylitol production experiment (Fig. 3). a, b Xylanase activity of single or double mutant strains on MA-medium supplemented with 2 % barley straw, respectively. c, d Xylanase activity of single or double mutant strains on MA-medium supplemented with 2 % barley straw in addition to 2 % d-glucose, respectively. e, f Xylanase activity of single or double mutant strains on MA-medium supplemented with 2 % barley straw in addition to 2 % d-xylose, respectively. Data are represented as the mean of two independent experiments, and error bars denote standard error of the mean
Enzymatic Hydrolysis of Biomass by the Mutant T. reesei Strains
Efficient hydrolysis is an important step in the bioconversion process where initially lignocellulosic polymers including cellulose and hemicelluloses break down to their monomeric soluble sugars [1]. Thus, many studies have been focused on improving lignocellulolytic activity of different microorganisms in addition to their ability to produce value added bio-products [1]. To this end, the hydrolysis efficiency of the two mutant T. reesei strains using barley straw was investigated here. In order to choose the right medium condition for the efficient hydrolysis activity, both strains were grown in different medium conditions, and their total cellulase activity as well as xylanase activity was monitored over a 168-h time course study (Fig. 5a–d). In this experiment, MA-medium was supplemented with 1 % MCC based on our previous study where the highest cellulase activity was obtained in three T. reesei strains [22].
Cellulases and xylanases activities of two mutant T. reesei strains grown on MA-media. a, b Cellulase activity of single or double mutant strains grown on MA-medium supplemented with either 1 % microcrystalline cellulose (MCC) or a combination of 1 % MCC and 1 % barley straw (untreated or pretreated), respectively. c, d Xylanase activity of single or double mutant strains grown on MA-medium supplemented with either1 % MCC or a combination of 1 % MCC and 1 % barley straw (untreated or pretreated), respectively. Data are represented as the mean of two independent experiments, and error bars denote standard error of the mean
Our results showed that high total cellulase activity was seen for both mutant strains only when grown on MA-medium supplemented with 1 % MCC or a combination of MCC and Organosolv-pretreated barley straw (Fig. 5a, b). Total cellulase activity reached 20.83 and 14.46 FPU/mL using MA-medium supplemented with either 1 % MCC or 1 % MCC plus 1 % Organosolv-pretreated barley straw for single or double mutant strains after 168 h of incubation, respectively (Fig. 5a, b). However, very low cellulase activity was obtained for both strains using MA-medium supplemented with 1 % MCC in combination with 1 % NaOH-pretreated barley straw. In the case of xylanase activity, however, overall very high activity was obtained for both strains under the same culture condition over the entire time point study (Fig. 5c, d). For the single mutant strain, the highest xylanase activity of about 281 IU/mL was obtained when MA-medium was supplemented with 1 % Organosolv-pretreated barley straw in addition to 1 % MCC (Fig. 5c). The double mutant strain showed higher xylanase activity at about 342 IU/mL using MA-medium only supplemented with 1 % MCC after 168 h of incubation (Fig. 5d). Since high cellulase activity as well as high xylanase activity were obtained for both mutant strains using MA-medium supplemented with 1 % MCC, the culture supernatants were used as the enzyme source for the following enzymatic hydrolysis of biomass experiment.
Hydrolysis efficiency of both mutant strains was tested using 3 % barley straw as the lignocellulosic biomass over a 120-h incubation time (Fig. 6a–f). For the untreated barley straw (Fig. 6a, b), both single and double mutant strains released the highest RS at the last time point (120 h) over the studied time points with about 200 and 230 mg/g, respectively. d-Glucose, d-xylose, and l-arabinose released by both strains using untreated barley straw were also monitored over the time points. The single mutant strain produced about 110, 41, and 5 mg/g d-glucose, d-xylose, and l-arabinose after 120 h of incubation while the double mutant strain was able to release about 115, 48, and 7 mg/g d-glucose, d-xylose, and l-arabinose after 120 h of incubation, respectively (Fig. 6a, b).
Enzymatic hydrolysis of barley straw by two mutant T. reesei strains. a, b Reducing sugars, d-glucose, d-xylose, and l-arabinose yield (in milligrams per gram) released by single or double mutant strains using untreated barley straw, respectively. c, d Reducing sugars, d-glucose, d-xylose, and l-arabinose yield (in milligrams per gram) released by single or double mutant strains using NaOH-pretreated barley straw, respectively. e, f Reducing sugars, d-glucose, d-xylose, and l-arabinose yield (in milligrams per gram) released by single or double mutant strains using Organosolv-pretreated barley straw, respectively. One thousand microliters of the culture supernatants previously grown on MA-medium supplemented with 1 % MCC (as the enzyme source) was added to tubes containing 1,000 μl of 50 mM sodium citrate buffer (pH 5.0) and 0.06 g (3 %) barley straw. The tubes were incubated at 50 °C for 120 h, and reducing sugars as well as d-glucose and d-xylose released were measured every 24 h. Data are represented as the mean of two independent experiments, and error bars denote standard error of the mean. Total protein loading of 0.5 mg (single or double mutant culture supernatant) was used, and the volume was adjusted by the buffer
Hydrolysis efficiency of both mutant strains was tested using Organosolv-pretreated barley straw (Fig. 6c, d). The results indicated that both strains released higher amounts of RS compared to untreated barley straw. The amount of released RS gradually increased over the time point study with the highest production of 592 and 600 mg/g after 120 h of incubation for single and double mutant strains, respectively (Fig. 6c, d). These were 2.96- and 2.59-fold higher than the maximum released RS from untreated barley straw by both single and double mutant strains, respectively. In the case of d-glucose, the maximum production of 537 and 479 mg/g was achieved for single and double mutant strains after 120 h of incubation. This suggests that Organosolv pretreatment significantly increased the accessibility of cellulose in barley straw leading to higher levels of release of d-glucose compared to untreated barley straw (Fig. 6c, d). In the case of d-xylose and l-arabinose, however, no detectable sugars were released by either strains indicating that most of the hemicellulose part of barley straw was removed following the Organosolv pretreatment. This is in good accordance with the results obtained by Pan et al. studies where most of the monomeric and oligomeric hemicellulosic sugars of Poplar became water-soluble after Organosolv pretreatment and separated from solid residue (mostly cellulose) [35].
Similar results with high released RS were also obtained when NaOH-pretreated barley straw was used as the substrate for the enzymatic hydrolysis experiment (Fig. 6e, f). After 120 h of incubation time, the maximum RS released was obtained for both single and double mutant strains (692 and 685 mg/g, respectively), which were 3.46- and 2.96-fold higher than the released RS from untreated barley straw by single and double mutant strains, respectively (Fig. 6e, f). The single mutant strain produced about 417, 177, and 17 mg/g d-glucose, d-xylose, and l-arabinose after 120 h of incubation which was 3.78-, 4.33-, and 3.2-fold higher than the released sugars using untreated barley straw, respectively. The double mutant strain, however, produced about 404, 155, and 17 mg/g d-glucose, d-xylose, and l-arabinose after 120 h of incubation which was 3.49-, 3.21-, and 2.42-fold higher than the released sugars using untreated barley straw, respectively (Fig. 6e, f).
Conclusion
In our study, we have used two T. reesei mutant strains as the cell factories for xylitol production. Barley straw was used as an example of agricultural residue. Barley straw was subjected to two pretreatment methods including NaOH and Organosolv pretreatment. High xylitol production was achieved when barley straw (untreated or pretreated) was supplemented with 2 % d-xylose whereas d-glucose supplement did not lead to any significant difference. The production reached to 6.1 and 13.22 g/L using medium supplemented with 2 % Organosolv-pretreated barley straw and 2 % d-xylose by single and double mutant strains, respectively. Saccharification of pretreated barley straw showed that NaOH pretreatment significantly increases the accessibility of cellulose/hemicellulose leading to a greater release of reducing sugars, d-glucose, d-xylose, and l-arabinose compared to untreated barley straw. Hydrolysis of Organosolv-pretreatment barley straw led to higher amounts of released d-glucose compared to untreated barley straw; however, no detectable d-xylose or l-arabinose was found in the hydrolyzates using both strains. This indicated that Organosolv pretreatment removed most available hemicellulose in barley straw. Organosolv pretreatment was more effective than NaOH pretreatment since it significantly increased xylitol production by both T. reesei strains. However, this was only the case when the medium was also supplemented with 2 % d-xylose. This suggests that beside the accessibility of xylan, d-xylose concentration is also important for the xylitol production. The results suggest that agricultural residues, such as barley straw, could be a suitable resource for bioconversion to produce value-added products such as xylitol.
Abbreviations
- ∆xdh1 :
-
Xylitol dehydrogenase gene deleted strain (T. reesei single mutant strain)
- ∆lad1∆xdh1 :
-
l-Arabinitol-4-dehydrogenase and xylitol dehydrogenase genes deleted strain (T. reesei double mutant strain)
- PPP:
-
Pentose phosphate pathway
- FTIR:
-
Fourier transform infrared spectroscopic
- HPAE-PAD:
-
High-performance anion exchange chromatography with pulsed amperometric detection
- DNS:
-
3,5-Dinitrosalicylic acid
- FPU:
-
Filter paper unit
- MCC:
-
Microcrystalline cellulose
- RS:
-
Reducing sugars
References
Dashtban, M., Schraft, H., & Qin, W. (2009). International Journal of Biological Sciences, 5, 578–595.
Yu, C., Cao, Y., Zou, H., & Xian, M. (2011). Applied Microbiology and Biotechnology, 89, 573–583.
Nygard, Y., Toivari, M. H., Penttila, M., Ruohonen, L., & Wiebe, M. G. (2011). Metabolic Engineering, 13, 383–391.
Seiboth, B., & Metz, B. (2011). Applied Microbiology and Biotechnology, 89, 1665–1673.
Taherzadeh, M. J., & Karimi, K. (2008). International Journal of Molecular Sciences, 9, 1621–1651.
Dashtban, M., Schraft, H., Syed, T. A., & Qin, W. (2010). International Journal of Biochemistry and Molecular Biology, 1, 36–50.
Seiboth, B., Hartl, L., Pail, M., & Kubicek, C. P. (2003). Eukaryotic Cell, 2, 867–875.
Seiboth, B., Gamauf, C., Pail, M., Hartl, L., & Kubicek, C. P. (2007). Molecular Microbiology, 66, 890–900.
Sato, H., Ide, Y., Nasu, M., & Numabe, Y. (2011). Odontology, 99, 28–33.
Prakasham, R., Rao, R., & Hobbs, P. (2009). Current Trends in Biotechnology and Pharmacy, 3, 8–36.
Santos, D. T., Sarrouh, B. F., Rivaldi, J. D., Converti, A., & Silva, S. S. (2008). Journal of Food Engineering, 86, 542–548.
Khankal, R., Chin, J. W., & Cirino, P. C. (2008). Journal of Biotechnology, 134, 246–252.
Ahmad, I., Shim, W. Y., Jeon, W. Y., Yoon, B. H., & Kim, J. H. (2012). Bioprocess and Biosystems Engineering, 35, 199–204.
Akinterinwa, O., Khankal, R., & Cirino, P. C. (2008). Current Opinion in Biotechnology, 19, 461–467.
El-Batal, I. A., & Khalaf, S. A. (2004). International Journal of Agriculture and Biology, 6, 1066–1073.
Rodrigues, R. C., Kenealy, W. R., & Jeffries, T. W. (2011). Journal of Industrial Microbiology and Biotechnology, 38, 1649–1655.
Cheng, S., D’Cruz, I., Wang, M., Leitch, M., & Xu, M. (2010). Energy Fuels, 24, 4659–4667.
Deshpande, P., Nair, S., & Khedkar, S. (2009). Applied Biochemistry and Biotechnology, 158, 552–560.
Mandels, M. M., & Andreotti, R. E. (1978). Process Biochemistry, 13, 6–13.
Gamerith, G., Groicher, R., Zeilinger, S., Herzog, P., & Kubicek, C. P. (1992). Applied Microbiology and Biotechnology, 38, 315–322.
Miller, G. L. (1959). Analytical Chemistry, 31, 426–428.
Dashtban, M., Buchkowski, R., & Qin, W. (2011). International Journal of Biochemistry and Molecular Biology, 2, 274–286.
Dashtban, M., Maki, M., Leung, K. T., Mao, C., & Qin, W. (2010). Critical Reviews in Biotechnology, 30, 302–309.
Dashtban, M., & Qin, W. (2012). Microbial Cell Factories, 11, 63.
Vidal, B. C., Jr., Dien, B. S., Ting, K. C., & Singh, V. (2011). Applied Biochemistry and Biotechnology, 164, 1405–1421.
Pedersen, M., & Meyer, A. S. (2009). Biotechnology Progress, 25, 399–408.
da Silva, A. S., Inoue, H., Endo, T., Yano, S., & Bon, E. P. (2010). Bioresource Technology, 101, 7402–7409.
Hsu, T. C., Guo, G. L., Chen, W. H., & Hwang, W. S. (2010). Bioresource Technology, 101, 4907–4913.
Chundawat, S. P., Venkatesh, B., & Dale, B. E. (2007). Biotechnology and Bioengineering, 96, 219–231.
Kumar, R., Mago, G., Balan, V., & Wyman, C. E. (2009). Bioresource Technology, 100, 3948–3962.
Wang, B., Wang, X., & Feng, H. (2010). Bioresource Technology, 101, 752–760.
Guo, G. L., Chen, W. H., Men, L. C., & Hwang, W. S. (2008). Bioresource Technology, 99, 6046–6053.
Prathumpai, W., McIntyre, M., & Nielsen, J. (2004). Applied Microbiology and Biotechnology, 63, 748–753.
Prakash, G., Varma, A. J., Prabhune, A., Shouche, Y., & Rao, M. (2011). Bioresource Technology, 102, 3304–3308.
Pan, X., Gilkes, N., Kadla, J., Pye, K., Saka, S., Gregg, D., et al. (2006). Biotechnology and Bioengineering, 94, 851–861.
Acknowledgments
The authors would like to thank Dr. Shuna Cheng and Dr. Chunbao (Charles) Xu for their great help with the Organosolv pretreatment. The authors would also like to thank Dr. Matthew Leitch for allowing us to use Wiley mill machine. This work was supported by a scholarship from Ontario Graduate Scholarship to M.D. and NSERC-RCD and Ontario Research Chair funding to W.Q.
Conflict of Interests
The authors declare that they have no competing interests.
Author information
Authors and Affiliations
Corresponding author
Rights and permissions
About this article
Cite this article
Dashtban, M., Kepka, G., Seiboth, B. et al. Xylitol Production by Genetically Engineered Trichoderma reesei Strains Using Barley Straw as Feedstock. Appl Biochem Biotechnol 169, 554–569 (2013). https://doi.org/10.1007/s12010-012-0008-y
Received:
Accepted:
Published:
Issue Date:
DOI: https://doi.org/10.1007/s12010-012-0008-y